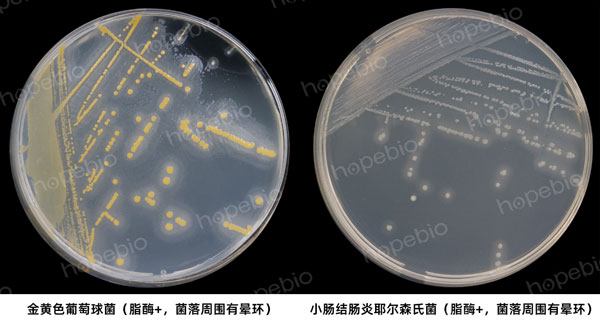

海博微信公众号
海博微信公众号
 海博天猫旗舰店
海博天猫旗舰店


 海博微信公众号
海博微信公众号
 海博天猫旗舰店
海博天猫旗舰店




一、试验简介
吐温80(聚山梨酯80)是由山梨糖醇酐单油酸酯和氧化乙烯反应制得的,淡黄色油状液体,易溶于水,常做为表面活性剂或中和剂使用。一些细菌可产生脂酶,将吐温80中水解出不溶于水的游离脂肪酸,在菌落周围形成晕圈。
二、培养基成分(g/L)
|
蛋白胨 |
10.0 |
|
氯化钠 |
5.0 |
|
氯化钙 |
0.1 |
|
琼脂 |
9.0-15.0 |
|
吐温80 |
10.0mL |
|
pH |
7.4±0.2 |
三、试验方法及结果
按组分配制培养基,加热溶解于纯化水中,121℃灭菌15min,倾入无菌平皿,凝固后备用(也可分装于试管摆斜面使用)。挑取待测菌落划线接种于平板,25℃或36℃(视菌种生长条件而定)培养2-7天,观察平板上菌落周围是否出现模糊的晕环。
注:本文属海博生物原创,未经允许不得转载。
下一篇:没有了!
| 相关文章: | ||



